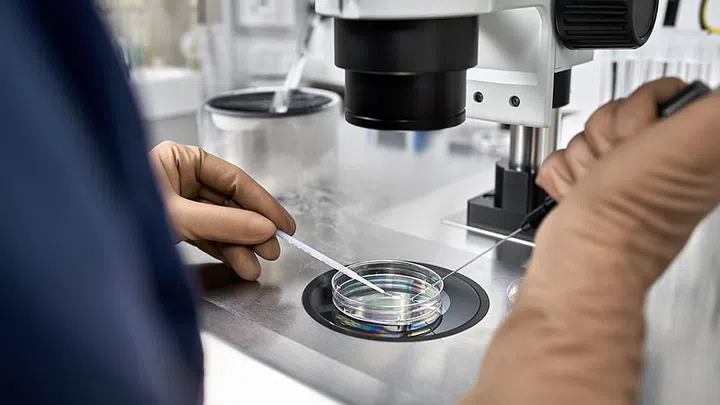

When the White Paper on Singapore's Women’s Development was released in late March, among the 25 action plans proposed, the upcoming changes to the egg-freezing policy in Singapore – that women aged 21 to 35 will be allowed to opt for elective egg freezing starting in 2023 – seemed to generate the most buzz, considering the profound impact they’ll likely have on women who might have been considering to undergo egg-freezing procedures overseas.

Credit: 123rf
The recent White Paper announcement will definitely increase options to women who are as yet single, says Dr Janice Tung, consultant obstetrician and gynaecologist at Thomson Fertility Clinic. “In future, after this is established in practice, an older woman seeking fertility treatment with younger eggs stored prior will most likely have better chances at having children. Women with non-cancer related gynaecological conditions, such as endometriosis, or dermoid cysts where surgery may potentially affect their fertility in future, would also benefit from utilising this option.”
Previously, egg-freezing was only possible for medical reasons such as in situations involving cancer, pre-chemotherapy, pre-radiotherapy, explains Dr Christopher Chong, a urogynaecologist and obstetrician & gynaecologist at Gleneagles Hospital, Singapore.
Describing egg-freezing as “an insurance policy,” Dr Andrew Kan, Fertility Specialist at Virtus Fertility Centre, says: “Like all insurance policies, we hope that we won’t need to use it. However, when we do use it, we hope that it will pay off, that is, the couple end up with a healthy baby [from using their] frozen thawed eggs.”
Would egg-freezing work for you, and what do you need to know before you sign up for the procedure? We speak to medical and fertility experts to get the full picture on what to expect.
The Procedure
Credit: 123rf
How to prepare
Dr Andrew Kan (AK): Women should try not to smoke, drink alcohol, or take any other exogenous medication if possible, during the ovarian stimulation. Ovarian stimulation usually starts with the woman’s menstruation and involves subcutaneous injections of hormonal medications that the patients can give themselves daily. After about 10 days of injections, most women will be ready for egg collection.
The process
Dr Janice Tung (JT): A final injection is administered to cause ovulation when the eggs are deemed to be sufficiently mature. Thirty-six hours later, egg collection is done under sedation.
This is where some medication is given through a drip to cause you to go to sleep, like taking a nap. You will not be aware, and should not feel any pain or remember the procedure. You do not move because you are asleep, not because you are paralysed (which is what happens in general anaesthesia instead). You will be monitored throughout the procedure. You will be instructed to fast for the sedation, as well as to empty your bladder beforehand.
A thin long needle is inserted into the ovaries internally through the vagina under ultrasound guidance and the eggs are extracted. This is a fairly low-risk and simple procedure that should take under half an hour to complete. There is no incision made, so no scars.
Post-Procedure
JT: After the procedure, you will be observed for a short period of time. Once you wake up, you should generally be more alert, able to pass urine, tolerate food or fluid intake and walk before being discharged. Patients do not usually require additional painkillers for the procedure.
Menstruation will usually come about one to two weeks after the procedure. During this interval, you may feel more bloated or heightened premenstrual symptoms. This is due to the effect of the injections which tend to peak in this period and not the procedure itself. These symptoms will dissipate on their own, especially when the menses comes.
AK: The collected eggs are examined under the microscope to make sure they are mature before they are frozen by the vitrification technique. This is a snap freezing process with liquid nitrogen. Each egg is frozen in its own straw and carefully labelled. They can be kept frozen as long as the liquid nitrogen is topped up from time to time. When needed, the egg is thawed at room temperature, then fertilised with the partner's sperm and then the resultant embryo is cultured for five days before embryo transfer.
Dr Christopher Chong (CC): Patients are recommended to rest on the first day post-procedure, and can resume their normal activities after one or two days.
Price
JT: Costs range from $6,000 to $7,500 for an egg collection procedure and freezing, exclusive of medications. The amount of medications used depends on the age of the woman and her egg count, and as such, an older woman or a woman with a low egg count may expect higher costs of medications. Furthermore, a second cycle and collection may be recommended to increase chances of conceivable success with IVF later.
Even if some overseas facilities appear to be less costly currently, women will have to consider the cost of courier, travel, and the utilisation of the eggs overseas for IVF. Hence, she should decide based on where she may find herself in the long-term. That said, local women would likely still benefit from cost-savings by doing the procedure in Singapore.
Lesser-Known Facts to Keep in Mind

Credit: 123rf
The possibility of complications
CC: Ovarian hyperstimulation (OHSS) is a side effect of the stimulation of the ovaries. This can cause the blood vessels to be more porous to fluid and this fluid moves out of the blood vessels. This can result in fluid in the abdomen, causing pain and discomfort, or fluid into tissue covering the lungs, causing difficulty in breathing, which can be very severe. In serious cases, a tube will have to be inserted into the lung space or abdominal space to drain out the fluid. Severe OHSS can be lethal.
The womb matters too
CC: When one freezes eggs when they are young, the egg age remains. However, the womb that carries the foetus will age. As the patient ages, so does the womb, and complications such as high blood pressure, diabetes, miscarriage, premature labour, growths such as fibroids (which can be complicated by increasing miscarriage risks and premature labour) increase – the older the woman, the higher the risks. If you freeze your eggs at 25, and try for an IVF pregnancy at, say, 45, it might not be ideal. The way out could be surrogacy, but this is at present illegal in Singapore.
Lower usage of frozen eggs
JT: Statistics have shown that the majority of women do not use the eggs that they have stored. One should bear in mind that she may not actually utilise the eggs in the end since she may be able to fall pregnant naturally regardless of age, so long as she has not reached menopause. A naturally conceived pregnancy would be less medicated than an IVF one.
Be prepared to invest without results
AK: Freezing one's eggs is by no means a guarantee that it will result in a healthy liveborn. Not all eggs survive the freezing and thawing process, not all successfully thawed eggs get fertilised, and not all fertilised eggs reach the day 5 embryo transfer stage. Hence, we need many eggs to start off with to increase the chance of a live birth downstream. It is often quoted in the literature that you need at least 20 eggs to have one successful live birth, depending on how old you were when the eggs were frozen.